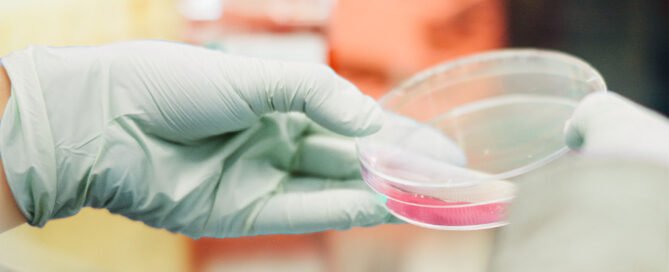
PROSENSO BIODEGRADABLE WITH CHEMICALS

Understanding EN374: A Comprehensive Guide to the Protective Glove Standard
Protective gloves play a crucial role in safeguarding workers from various hazards in the workplace. The EN374 standard has become the cornerstone for evaluating and certifying the performance of protective gloves against chemicals and microorganisms. This comprehensive guideline impacts